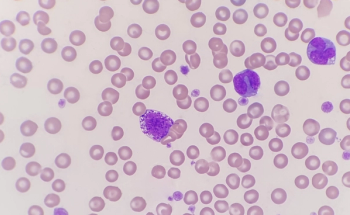
Mast cells under a microscope

Plus, how to address those that are normal but still a nuisance.

How veterinary technicians can "save the day" by educating cat owners on the dangers of parasites and importance of prevention

Josephine the dog eats her pet owner’s cancer cream left on counter only to realize the dire consequences

North Carolina State University found that dogs who slow down physically also slow down mentally

Under a microscope, samples collected from the rectum can yield answers to gastrointestinal signs in patients

Nucleic acid vaccines induce 2 immune defenses to protect against infection and disease

A research abstract presented at 2023 ACVIM Forum emphasized the importance of parasite prevention as treatments don’t prevent long-term complications

Two research abstracts offer new data on widespread prevalence in North America

How this dog was successfully treated plus other pet dangers to be mindful of this summer

Pair traditional and holistic treatments for the most successful patient outcomes
Zomedica’s TRUVIEW offers advanced optics, automated slide preparation, and telepathology services.

Conditionally approved by the FDA, fuzapladib sodium for injection is a leukocyte function-associated antigen-1 activation inhibitor.

In this dvm360® interview, Dr Mariana Pardo shares how to approach a thoracic trauma patient

In this dvm360® interview, Dr Leilani Alvarez shares a pearl of wisdom she's learned during her career

3 articles recapping pain management lectures from the Directions in Veterinary Medicine symposium in Miami, Florida

In this dvm360® interview, Dr Mariana Pardo describes the invaluable insight ultrasounds can provide veterinarians

Trio of faculty collaborated to discuss management of painful joint conditions in companion animals at the Directions in Veterinary Medicine symposium in Miami, Florida

In this dvm360® interview, Dr Leilani Alvarez explains how she uses this therapy for pets as part of a multimodal approach to pain management

In this dvm360® interview, Dr Bryce Dooley discusses effective drug options for these patients in excruciating pain

In this dvm360® interview, Dr Mariana Pardo shares insight on when faced with this type of potentially critical patient

In this dvm360® interview, Tasha McNerney, BS, CVT, CVPP, VTA (Anesthesia and Analgesia), explains when its appropriate to use constant-rate infusions

Day 1 of the Directions in Veterinary Medicine symposium in Miami kicks off with lecture on addressing this mock pain management case

In this dvm360® interview, Dr Leilani Alvarez shares what to keep on your radar for 2023 and beyond

In this dvm360® interview, Dr Matthew Brunke shares how to address this oftentimes underdiagnosed condition in pets

In this dvm360® interview, Dr Bryce Dooley outlines helpful adjunct therapies and educates us on taking an individualized approach

In this dvm360® interview, Dr Bryce Dooley shares what to bear in mind when administering this pain management drug

In this dvm360® interview, Dr Bryce Dooley outlines the most effective analgesics for cat patients

Ashley Bourgeois, DVM, DACVD, shares her experience of balancing being a mom with her career as a veterinarian

How better allergy testing allows for a more targeted approach when it comes to the itchy pet

dvm360 Live!™ kicks off its second season